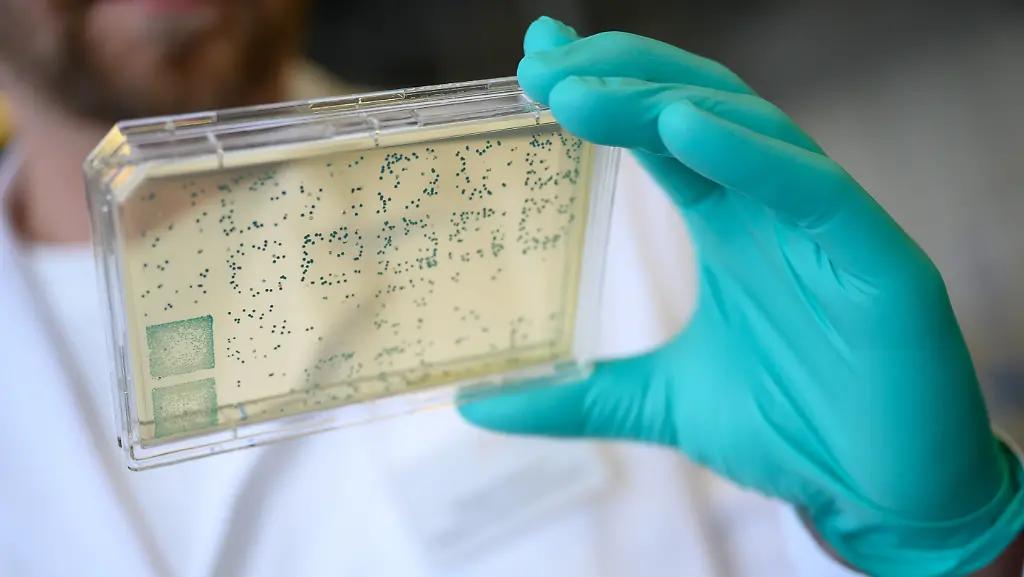
131041848

Rennen um Corona-ImpfstoffMerkel erklärt CureVac-Streit für beendet
Ein Impfstoff gegen das Coronavirus würde weltweit für Erleichterung sorgen. Angeblich zeigen die USA deshalb Interesse an einem Exklusivvertrag mit dem Tübinger Unternehmen CureVac. Dazu kommt es nicht - auch nach Protest der Bundesregierung. Von der EU erhält CureVac eine Millionen-Förderung.
Bundeskanzlerin Angela Merkel betrachtet die Auseinandersetzung mit den USA um die Tübinger Impfstoff-Firma CureVac für beendet. "Letzteres hat heute keine Rolle gespielt, zumal das Thema ja auch gelöst ist, wie wir am Wochenende ja sagen konnten", sagte Merkel in Berlin. Die Bundesregierung habe sich "da ja sehr frühzeitig darum gekümmert". Die Kanzlerin verwies auch auf Äußerungen des Unternehmers Dietmar Hopp und der Firmenspitze, wonach ein Exklusivvertrag etwa mit den USA für einen Corona-Impfstoff für CureVac nicht infrage komme.
Die Europäische Kommission will CureVac bei der Entwicklung eines Mittels gegen das Coronavirus unterstützen. "Die EU hat deren Forschung früh unterstützt und wird nun wieder finanziell helfen", teilte Kommissionspräsidentin Ursula von der Leyen in Brüssel mit, nachdem sie und Forschungskommissarin Mariya Gabriel mit CureVac telefoniert hatten.Von der EU soll es Kredite von "bis zu 80 Millionen Euro" geben, um die Suche nach einem Impfstoff gegen das Coronavirus zu beschleunigen. Wie die EU-Kommission weiter mitteilte, soll die finanzielle Unterstützung über ein per EU-Garantie abgesichertes Darlehen der Europäischen Investitionsbank (EIB) erfolgen.
Den Angaben zufolge hat CureVac bereits ein laufendes Entwicklungsprogramm für einen Impfstoff gegen Covid-19 und will klinische Tests im Juni starten. Laut von der Leyen geht es darum, so schnell wie möglich einen Impfstoff zu finden, "der der ganzen Welt hilft". In den USA haben derweil erste klinische Tests für einen neuen Coronavirus-Impfstoff begonnen. Wie die US-Gesundheitsbehörde National Institutes of Health (NIH) mitteilte, bekam ein erster Versuchsteilnehmer den neu entwickelten Impfstoff. Insgesamt solle der Test über rund sechs Wochen an 45 gesunden Erwachsenen im Alter zwischen 18 und 55 Jahren laufen. Am Wochenende hatte es Berichte gegeben, wonach die USA exklusiv die Rechte an einem Impfstoff gegen das Coronavirus von CureVac erwerben wollten.
CureVac: "Ein Angebot liegt uns nicht vor"
Der mutmaßliche Versuch der US-Regierung hatte auch den Kreis der G7-Staaten beschäftigt. Darüber habe er bereits mit seinen Kollegen aus Kanada, Südkorea, Brasilien und Australien gesprochen, sagte Außenminister Heiko Maas den Zeitungen der Funke Mediengruppe. "Deutsche Forscher sind führend an der Entwicklung von Medikamenten und Impfstoffen beteiligt, in weltweiten Kooperationen. Wir können nicht zulassen, dass sich andere ihre Forschungsergebnisse exklusiv aneignen wollen." Ein CureVac-Sprecher sagte: "Ein Angebot liegt uns nicht vor."
Das Biotech-Unternehmen teilte der "Schwäbischen Zeitung" mit, eine Übernahme durch ein amerikanisches Unternehmen oder durch die USA stehe nicht im Raum. Zwar bestehe durchaus Interesse aus den USA an der Arbeit von CureVac, aber "Corona ist ein weltweites Problem, dafür arbeiten wir", sagte Franz-Werner Haas, der für die Produktion verantwortliche Vorstand bei CureVac. Seit Januar forscht CureVac an einem Impfstoff gegen das Coronavirus.
Das Bundeswirtschaftsministerium bekräftigte die grundsätzliche Bedeutung eines freien Zugangs zu einem möglichen Impfstoff gegen das Coronavirus. "Die Bundesregierung hat ein hohes Interesse, dass wir Wirkstoffe und Impfstoffe in Deutschland und Europa produzieren", sagte eine Sprecherin des Ministeriums. Zuerst hatte die "Welt am Sonntag" über Auseinandersetzungen um CureVac berichtet. US-Präsident Donald Trump versuche, deutsche Wissenschaftler mit hohen finanziellen Zuwendungen nach Amerika zu locken oder das Medikament exklusiv für sein Land zu sichern, berichtete die Zeitung unter Berufung auf Regierungskreise in Berlin.
Kein Exklusivvertrag mit den USA Deutsches Mittel nur für USA?
Ein hochrangiger Vertreter der US-Regierung bestätigte den Zeitungsbericht am Sonntagabend nicht. Er teilte auf Anfrage mit, man kenne weder den Bericht der "Welt am Sonntag" noch die zugrundeliegenden Informationen. Der US-Botschafter in Berlin, Richard Grenell, bezeichnete den Bericht auf Twitter als unwahr. Der Geschäftsführer und Mitbegründer des Hauptinvestors dievini Hopp BioTech Holding, Christof Hettich, hatte nach einem Bericht der Zeitung "Mannheimer Morgen" klargestellt, dass ein Exklusivvertrag etwa mit den USA für einen Corona-Impfstoff für CureVac nicht infrage komme. Der SAP-Mitbegründer und Mäzen Hopp und der Unternehmer Friedrich von Bohlen gehören dem Bericht zufolge zu den Gründern und Geschäftsführern der Firma.
CureVac forscht derzeit an einem Impfstoff gegen das Coronavirus und hat dafür 8,3 Millionen US-Dollar Fördergeld (rund 7,5 Millionen Euro) von der Internationalen Impfstoff-Allianz CEPI ("Coalition for Epidemic Preparedness Innovations") bekommen. Auch die Bundesregierung ist Mitglied von CEPI.